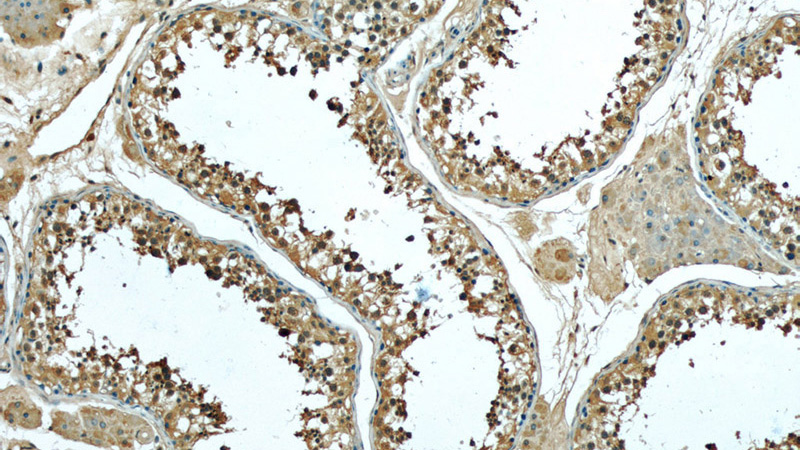
Immunohistochemistry of paraffin-embedded human testis slide using Catalog No:107607(STMN1 Antibody) at dilution of 1:50

-
Product Name
Stathmin antibody
- Documents
-
Description
Stathmin Mouse Monoclonal antibody. Positive WB detected in Jurkat cells, human brain tissue, K-562 cells. Positive IF detected in mouse olfactory epithelium tissue. Positive IHC detected in human testis tissue. Observed molecular weight by Western-blot: 18kD
-
Tested applications
ELISA, WB, IHC, IF
-
Species reactivity
Human, Mouse; other species not tested.
-
Isotype
Mouse IgG1
-
Preparation
This antibody was obtained by immunization of Stathmin recombinant protein (Accession Number: NM_203399). Purification method: Protein G purified.
-
Clonality
Monoclonal
-
Formulation
PBS with 0.02% sodium azide and 50% glycerol pH 7.3.
-
Storage instructions
Store at -20℃. DO NOT ALIQUOT
-
Applications
Recommended Dilution:
WB: 1:500-1:5000
IHC: 1:20-1:200
IF: N/A
-
Validations

Jurkat cells were subjected to SDS PAGE followed by western blot with Catalog No:107607(STMN1 antibody) at dilution of 1:1000
Immunohistochemistry of paraffin-embedded human testis slide using Catalog No:107607(STMN1 Antibody) at dilution of 1:50

Fluorescent IHC on 1%PLP fixed frozen mouse olfactory epithelium tissue of STMN1 antibody (Catalog No:, 1:200). Basal cell staining and dendritic processes as expected. By Dr. Brian Lin (Schwob Lab).
-
Background
Stathmin 1 (STMN1) normally regulates microtubule dynamics either by sequestering free tubulin heterodimers or by promoting microtubule catastrophe. STMN1 is highly expressed in fetal and adult brain, spinal cord, and cerebellum. Many different phosphorylated forms are observed depending on specific combinations among the sites which can be phosphorylated. Phosphorylation of stathmin is involved in response to NGF, neuron polarization and microtubule polymerization inhibition activity. Increased expression of STMN1 has been observed in a variety of human malignancies, such as colorectal primary tumors and metastatic tissues, but its association with melanoma is so far not well known.
Related Products / Services
Please note: All products are "FOR RESEARCH USE ONLY AND ARE NOT INTENDED FOR DIAGNOSTIC OR THERAPEUTIC USE"
